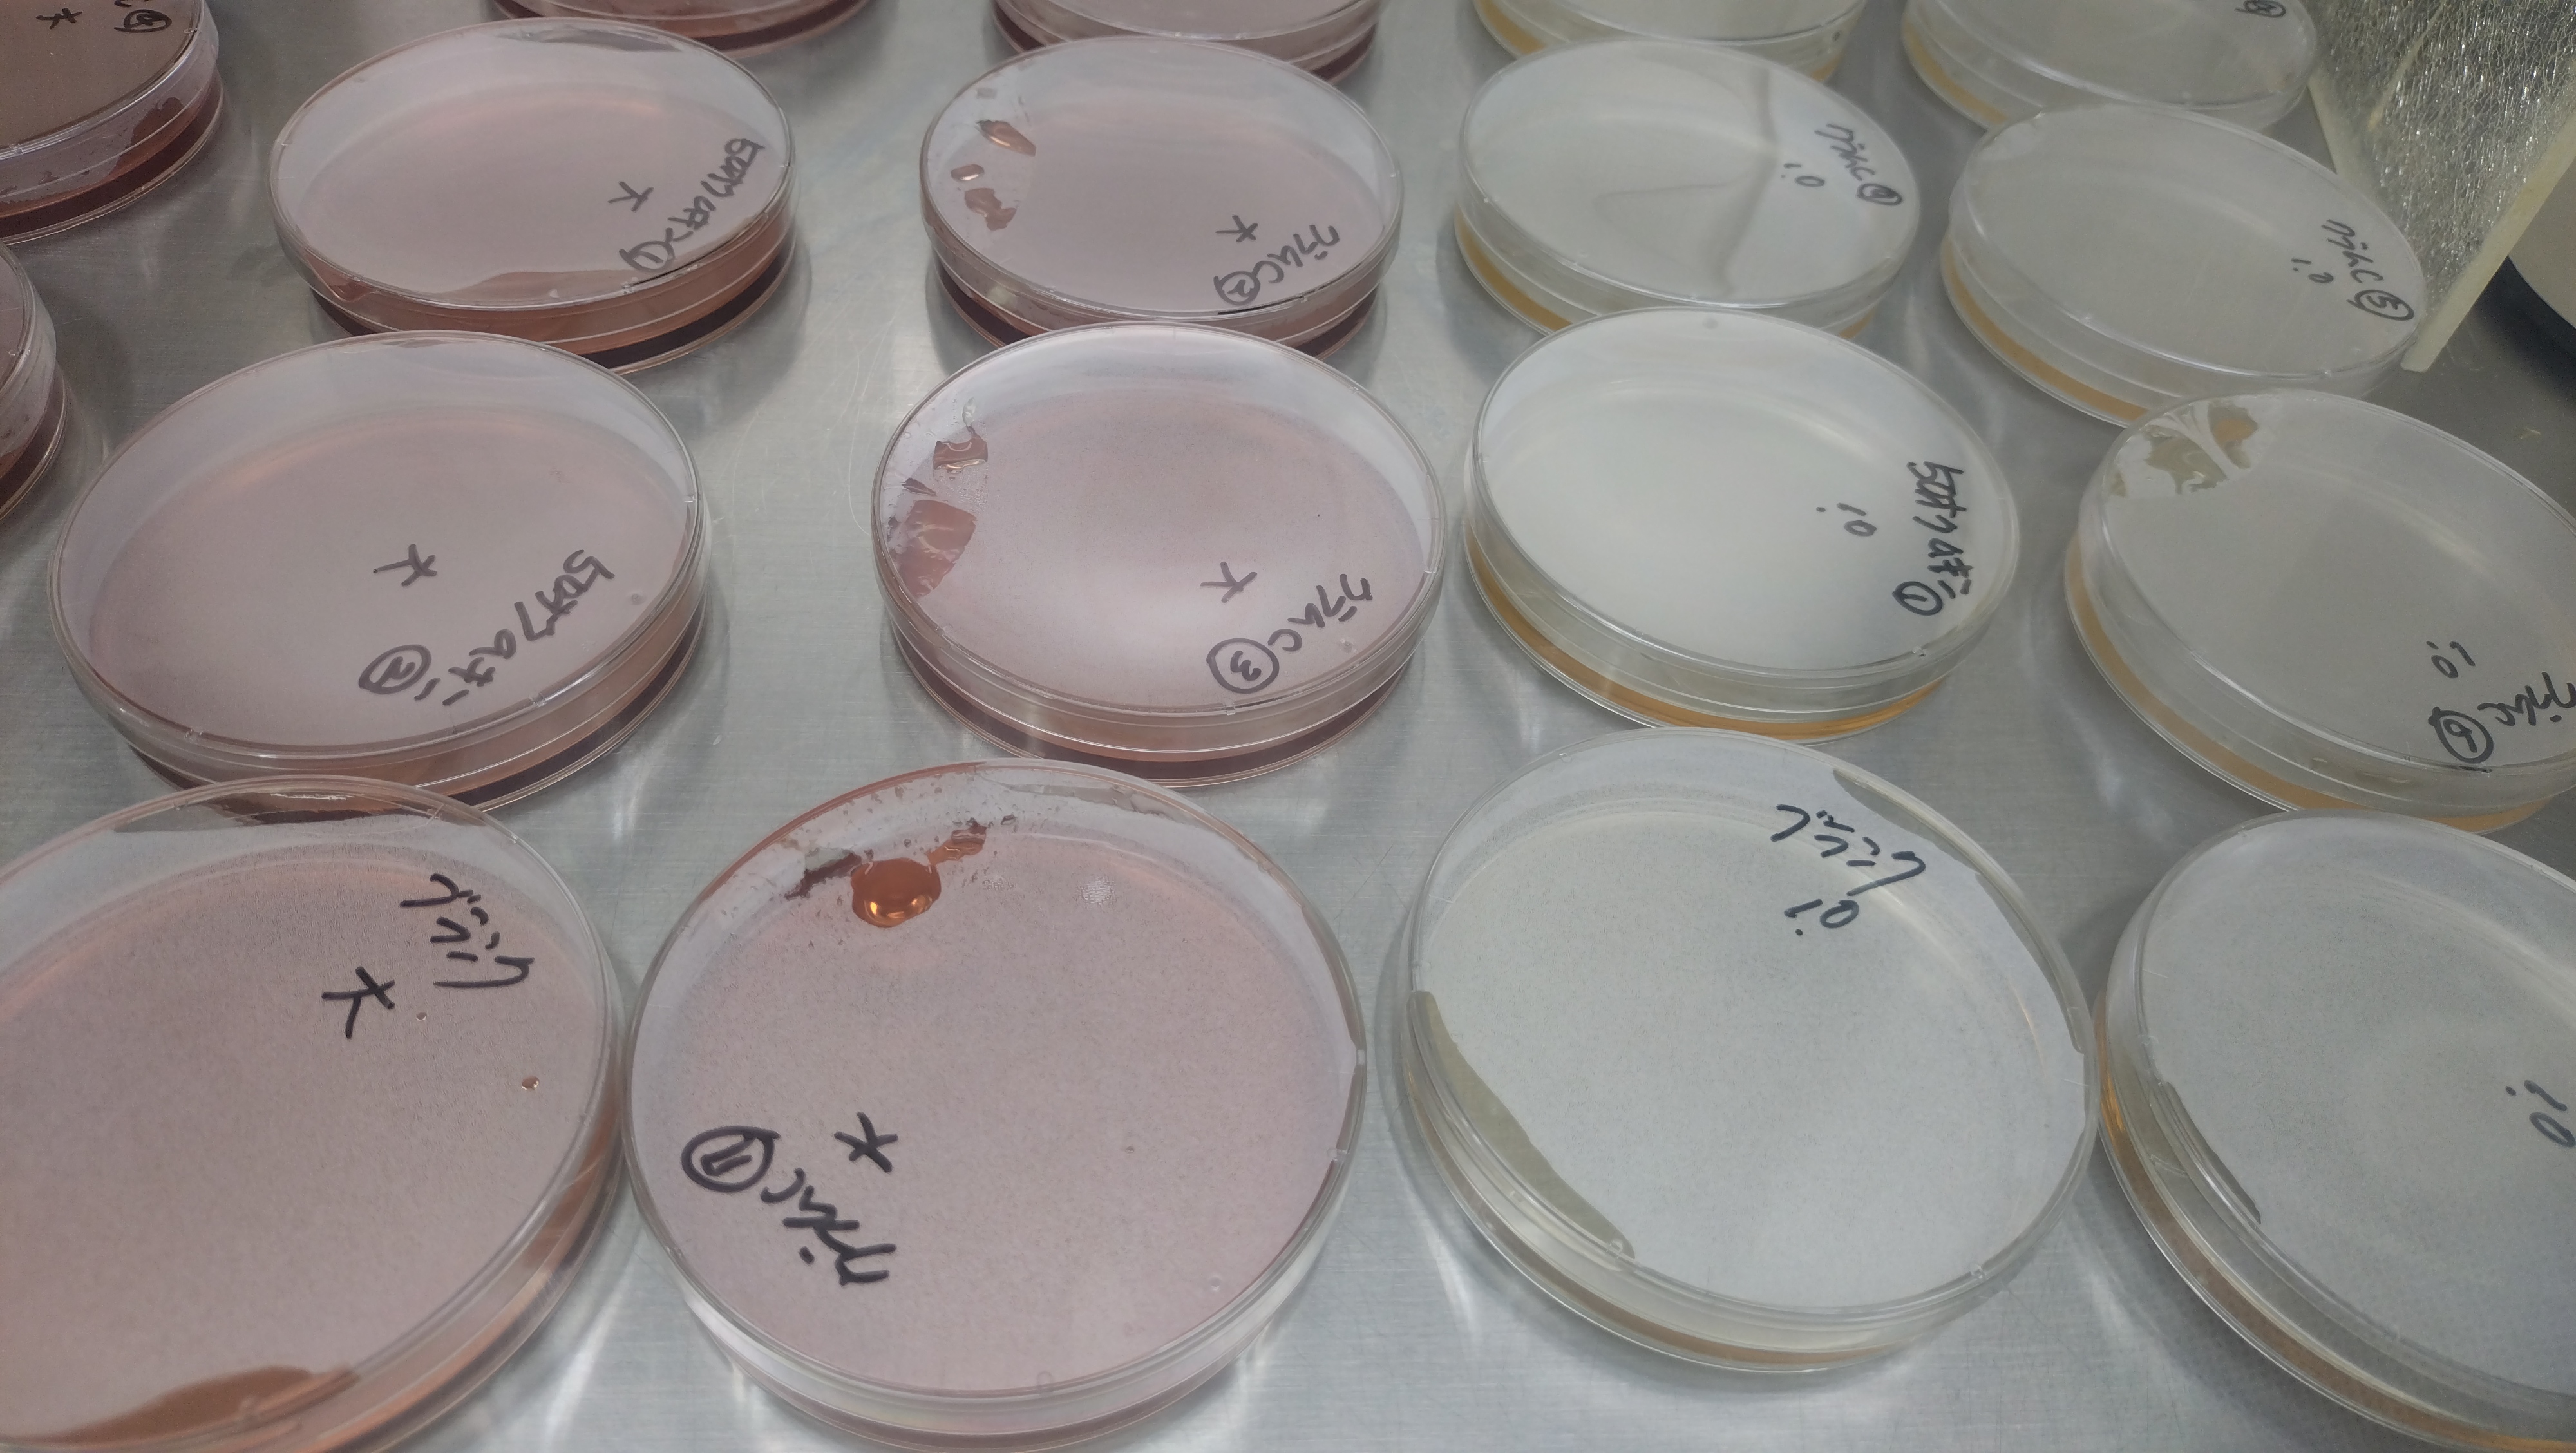
食べ物ではありません。

製造現場から
- フィブロ製薬株式会社赤坂ロハス箙(えびら)です。
赤坂ロハスが皆様にお届けしている「イサゴールシリーズ」、これはフィブロ製薬の看板製品。
弊社の前代表がインドでこの素材を見つけ、特定保健用食品として認可申請するにあたり何度も治験を行って有効性を確かめ誕生しました。
皆様にご愛顧いただいている「イサゴール」がどのような体制で製造しているか、どれだけの工程を進めているかなどをぜひ皆さんに知っていただく機会になればと思い、製造現場の取材をしてきました。 

- 安心安全のための努力
東京都足立区にあるフィブロ製薬本社工場では、イサゴールを充填製造を行っています。
皆様にお届けする製品を安心安全に手に取っていただけるよう、当社の経営理念をもとに製造体制を構築してます。
町工場だからこその工夫と努力をお伝えできればと思います。
私たちの経営理念です。
この経営理念をもとに、私たちの製造・生産工程を確立しています。